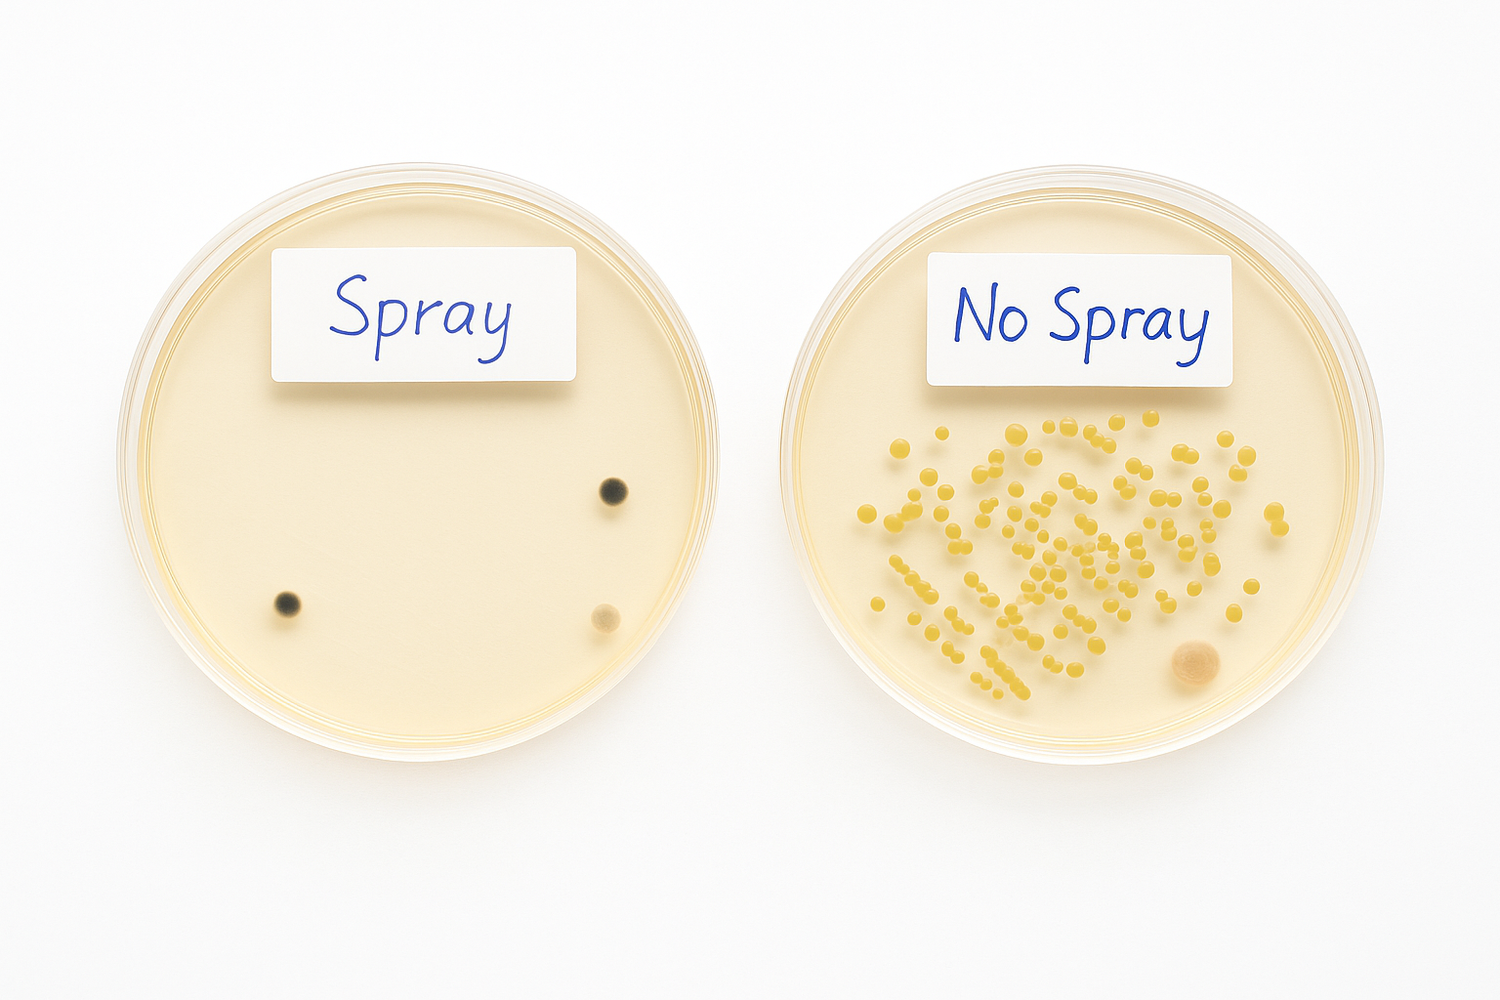

Wat is bluelighttechniek?
De bluelighttechniek is een geavanceerde methode waarbij blauw licht (LED) wordt gebruikt om op een veilige en effectieve manier bacteriën, virussen en schimmels te doden. Dit gebeurt zonder gebruik van chemische middelen of schadelijke stoffen.
Blauw licht heeft een specifieke golflengte (rond de 405–470 nanometer) die schadelijk is voor bepaalde micro-organismen.
Wanneer deze lichtstralen op het oppervlak schijnen, dringen ze door tot in de celstructuur van bacteriën of virussen en verstoren daar hun werking. Hierdoor gaan ze dood of kunnen ze zich niet meer vermenigvuldigen.

Hoe werkt het?
De bluelighttechniek maakt gebruik van krachtig blauw LED-licht. Dit licht:
- Activeert zuurstofmoleculen (reactieve zuurstofsoorten)
- Die zuurstof zorgt ervoor dat bacteriën van binnenuit worden vernietigd
- Dit gebeurt zonder schade aan gezonde cellen of materialen
Het is een volledig pijnloze en contactloze methode, waardoor het ook ideaal is voor gevoelige toepassingen.
Waar wordt bluelight voor gebruikt?
De bluelighttechniek wordt onder andere gebruikt voor:
- Desinfectie van oppervlakken of lucht (bijv. in medische ruimtes of laboratoria)
- Behandeling van wonden of infecties (bijvoorbeeld om bacteriën te doden bij een wond)
- Sterilisatie van medische instrumenten
- Preventie van infecties op moeilijk bereikbare plaatsen
- Verwijderen van biofilm op apparatuur of in waterleidingen

Is het veilig?
Ja. De bluelighttechniek is klinisch onderzocht en bewezen veilig in gebruik. Omdat het om specifieke lichtgolven gaat, worden alleen de schadelijke micro-organismen aangepakt, terwijl de rest ongemoeid blijft. Er komt geen hitte of straling vrij zoals bij uv-licht, en er is geen risico voor de huid of gezondheid bij correct gebruik.
Werkt het echt?
Ja! Wij hebben de ingebouwde bluelight-lamp uitgebreid getest. Uit onze test blijkt dat de lamp effectief actief wordt zodra je het apparaat gebruikt.
Het UV-licht helpt bij het afbreken van bacteriën en draagt zo bij aan een extra hygiënische reiniging.
Dankzij deze test weet je zeker dat de lamp niet alleen aanwezig is, maar ook écht doet wat hij belooft.